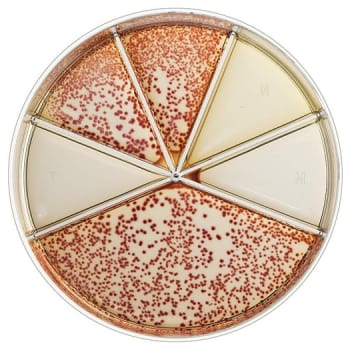
Flexicult, urinkit, agar plade, m 5 antibiotika, humant brug

Flexicult er et pålideligt dyrkningskit udviklet til hurtig og præcis diagnosticering af urinvejsinfektioner. Kittet muliggør samtidig følsomhedsbestemmelse af patogene bakterier over for en række antibiotika, hvilket understøtter en målrettet behandling.
Mere information om Flexicult:
- Effektiv diagnosticering – anvendes til at identificere bakterier i urinprøver
- Resistensbestemmelse – tester bakteriers følsomhed over for:
- Trimetoprim
- Sulfamethizol
- Ampicillin-PCD
- Nitrofurantoin
- Mecillinam
- Nem anvendelse – velegnet til laboratorier og kliniske miljøer
- Holdbarhed og opbevaring – skal opbevares på køl og har en begrænset holdbarhed
Sådan anvender du Flexicult dyrkningskit:
Flexicult anvendes i kliniske laboratorier til dyrkning af urinprøver og resistensbestemmelse. Efter podning inkuberes kittet, hvorefter vækstmønstre og antibiotikafølsomhed vurderes. Husk at kontrollere holdbarhedsdatoen før brug for at sikre pålidelige resultater.
Udviklet til præcis og hurtig diagnosticering
Flexicult er designet til sundhedsfagligt personale, der har behov for en hurtig, effektiv og præcis metode til påvisning af urinvejsinfektioner og resistensbestemmelse. Produktet hjælper med at optimere behandlingsvalg og forbedre patientplejen.